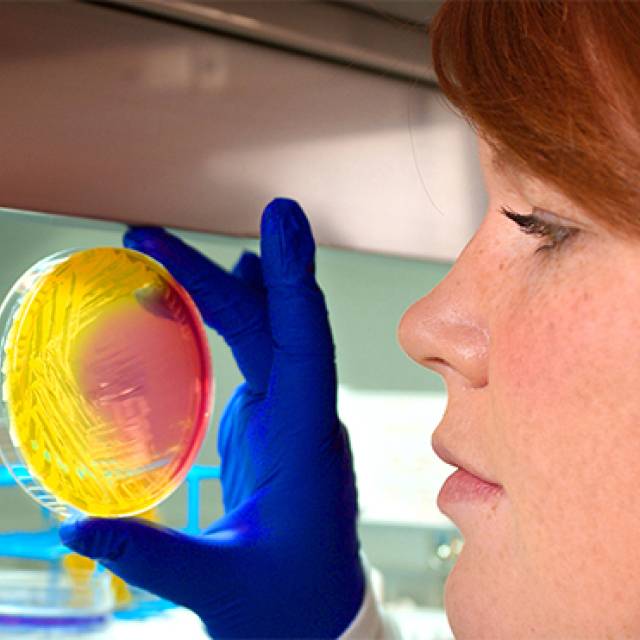

You are here
Planned and Legacy Gifts
What is a Planned Gift?
A planned gift is a way to support the CDC Foundation in the future through arrangements you make today. Planned giving allows you to make charitable gifts, continue to meet your current income needs and take advantage of current tax incentives.
These pages are designed to make it easy for you to get the information you need when considering a planned gift. You will also find information to share with your financial advisor and estate planner. When you are ready, you can use the links to reach out to us to share your plans, let us know what you are considering, or just to start a confidential, no-obligation conversation about what's possible.
The CDC Foundation is committed to helping you accomplish your charitable and financial goals through planned giving. Your gift will be met with attentive, personal service by staff members who seek to match your commitment to your philanthropic wishes. Learn about our most popular planned giving vehicles below or contact us for more information.
Subscribe to Planned Giving Newsletter
Here's How We Can Help
The CDC Foundation has invested in the resources below to make it simple to leave a lasting legacy today by including the CDC Foundation in your estate plans.
What is the Healthy Futures Society?
The Healthy Futures Society recognizes individuals and families that have included the CDC Foundation in their will or other estate plans. The generosity and foresight of these donors to leave a lasting legacy enables the CDC Foundation to continue the lifesaving work in support of the Centers for Disease Control and Prevention (CDC).
Information contained herein was accurate at the time of posting. The information on this website is not intended as legal or tax advice. For such advice, please consult an attorney or tax advisor. Charitable giving vehicles described herein are offered only in areas where permitted by law. Figures cited in any examples are for illustrative purposes only. References to tax rates include federal taxes only and are subject to change. State law may further impact your individual results.